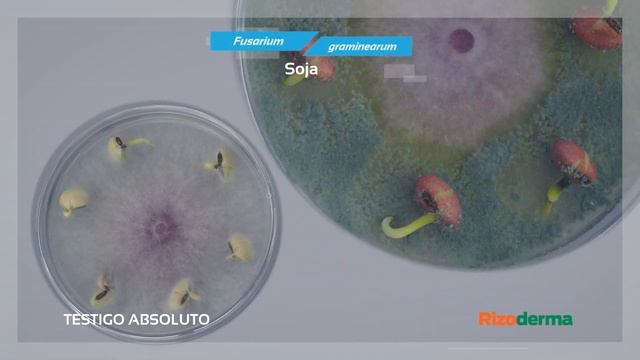
#RizodermaTimeLapse - Episodio 4 - Rizoderma Vs. Fusarium Graminareum

Лесные краски - Новые видео
-
-
-
#RizodermaTimeLapse - Episodio 4 - Rizoderma Vs. Fusarium Graminareum
Vas a descubrir la acción de Rizoderma como agente de control biológico para manejar los patógenos que causan enfermedades en soja. Podés ver los mecani...
Смотреть -
E-coli - Rife Frequency
E-coli - Rife Frequency - Relief can be found listening to frequencies, with or without headphones. Rife Frequencies - The Rife machine was developed ...
Смотреть -
085 320 602 958 | Obat Herbal Jian Xin Capsule | Jian Xin Capsule Green World
Kunjungi juga Website saya untuk mendapatkan Informasi Lainnya di http://tokoherbalampuh.web.id/ 081.320.078.000 | Obat Herbal Jian Xin Capsule | Jian...
Смотреть -
THRIVE MARKET HAUL | SO MUCH *VEGAN* CHOCOLATE
Hi. This, obviously, isn't sponsored bc im not famous and I spent all of my own money on this stuff lol. I did a Thrive Market Haul because I love food...
Смотреть -
-
BEGINI CARA MENGGORENG TEMPE BIAR RASANYA KRIUK
Tempe adalah makanan khas Indonesia yang terbuat dari fermentasi kedelai atau beberapa bahan lain yang menggunakan beberapa jenis kapang Rhizopus, seper...
Смотреть -
-
Keto Lasagna, Keto Chocolate Mint Cookies, And Zucchini W/Feta
Join my private Facebook Group click here.... Facebook.com/groups/healthyKetoInTheKellieKitchen For recipes and more go to www.TheKellieKitchen.com
Смотреть -
-
-
СТРИМ ПО РОБЛОКС\ИГРАЕМ\ОБЩАЕМСЯ🎉🎉
Ссылка на донатик - https://www.donationalerts.com/r/egor... ====ПРАВИЛА==== 1.1 Не матерится- Мут 300 сек повтор бан 1.2 Не оскорблять никого - бан...
Смотреть -
What Is Trichoderma | Why Use Trichoderma | ट्राइकोडर्मा क्या है | Hindi / English |
What is trichoderma | Why use trichoderma | ट्राइकोडर्मा क्या है | Hindi / English | juganu sir | juganu sir agrovet farming | juganu trichoderma use i...
Смотреть -
Используйте съедобные расходуемые предметы. От MorisMos
Укажите код автора в Игре FORTNITE: MORISMOS Буду рад копейкам: https://www.donationalerts.com/r/mrmos Мой канал на твиче: https://www.twitch.tv/moris...
Смотреть -
Обращение Генерального директора
Обращение Павла Матвеева - Генерального директора компании "Вентиляционные системы" Сайт компании: http://vent78.ru
Смотреть -
-
-
УГАДАЙ ПЕСНЮ ПО КАРТИНКАМ ЧЕЛЛЕНДЖ | ГДЕ ЛОГИКА?! | УГАДАЙ ПЕСНЮ CHALLENGE / Угадай строчку из песн
●Instagram → https://www.instagram.com/love._.funy/ ●Я ВКонтакте → https://vk.com/lolbodya ●Periscope → https://www.pscp.tv/Bodya_Jesus/follow ●Группа ...
Смотреть -
The Last Of Us Remastered PS5™ Walkthrough Gameplay Part 11 - ELLIE FIGHTS DAVID !! (No Commentary)
This video features Part 11 of The Last Of Us Remastered PS5™ Walkthrough Gameplay played in stunning 4K 2160p resolution WITHOUT commentary. It would b...
Смотреть